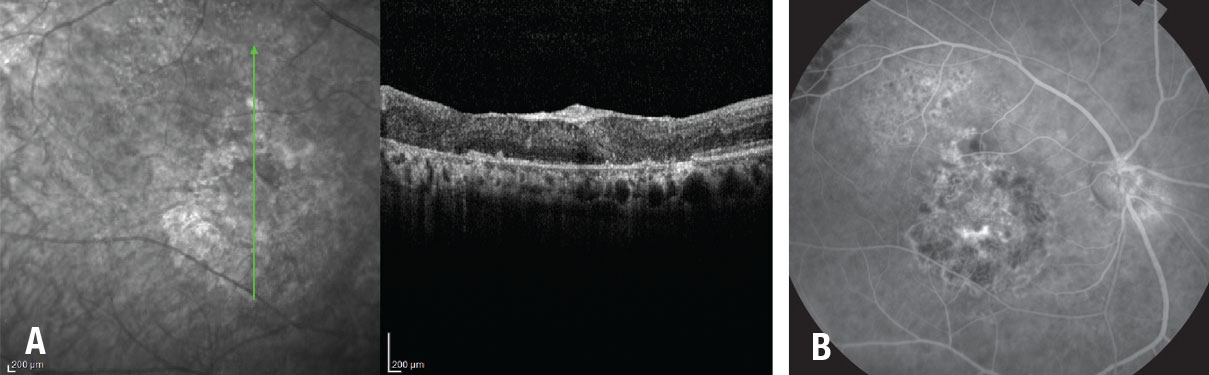

Take-home points
|
 Homayoun Tabandeh, MD |
|
Bios Dr. Tabandeh is a vitreoretinal surgeon and a partner at the Retina-Vitreous Associates Medical Group, Los Angeles, California. DISCLOSURES: Dr. Tabandeh has no conflicts to disclose. |
View the Video |
Pars plana vitrectomy peeling of the internal limiting membrane with gas tamponade is the most common surgery for primary macular holes (Figure 1). It has been associated with an anatomic success rate around 90 percent, but the outcomes are significantly less favorable for refractory MHs.1 The incidence of refractory MH has been reported to be 4.2 to 11.2 percent following PPV with or without ILM peel.1
To improve outcomes for MHs at higher risk of nonclosure, including refractory macular holes, various authors have described a number of different surgical approaches. These include in-office fluid-gas exchange or PPV/gas with prolonged face-down positioning, long-term tamponade with silicone oil, adjunct use of autologous blood or serum, manipulation of the MH rim and the surrounding retina, localized macula detachment, free or inverted ILM flaps, autologous lens capsule grafts, autologous retinal transplantation, amniotic membrane plug and macular buckle.1-12
ILM peel
Depending on whether the ILM has been removed completely from around the MH in a previous surgery, further ILM peel or removal may be indicated. ILM removal reduces the tangential traction at the inner retina surface and increases retina tissue compliance. Advantages of ILM peel include a higher primary closure rate, reduced chance of late reopening (from 7.1 to 1.2 percent) and reduced rate of epiretinal membrane formation.13,14
Potential disadvantages of ILM peel are surgical trauma, including dissociated optic nerve fiber layer, localized NFL damage, deep inner retina dimples and potential risk of chromophore toxicity. An extensive ILM peel may not be necessary for improved closure rate. Limiting the peel area to about 1 to 2 disc diameters reduces surgical trauma risk and leaves accessible residual ILM for a future distal ILM flap in cases of nonclosure.
Inverted ILM flap technique
 |
|
Figure 1. Indocyanine green fluorescence imaging in a patient following pars plana vitrectomy and internal limited membrane removal for a macular hole shows hyperfluorescence originating from the residual ILM. The dark circular area of relative hypofluorescence corresponds to the area of removed ILM. A smaller area of hyperfluorescence corresponds to the base of the MH. |
Zofia Michalewska, MD, and colleagues first described the inverted ILM flap technique that involved peeling the ILM from the central macular region, leaving the base attached to the MH rim.1 They trimmed the ILM flap and inverted it over the MH. They later described a temporal variation on this maneuver in which they peeled the ILM only over the temporal macula, reducing the potential risks of ILM peel.2 They reported a high closure rate with both techniques.
Stanislao Rizzo, MD, and colleagues compared ILM peel to the inverted ILM flap technique for primary repair of idiopathic and myopic MHs.15 They reported this technique was associated with a higher anatomic closure in large MHs (> 400 µm; 96 vs. 79 percent) and myopic MHs (88 vs. 39 percent).15 Other studies reported improved anatomic outcomes with the flap technique but with variable visual acuity outcomes.
Although conventional and temporal inverted ILM flap techniques were originally described for primary MHs, they may be used in refractory MH cases in which a previous operation left ILM. In cases of persistent MH following a previous ILM flap, the procedure may be repeated if the flap is intact. Alternatively, the residual ILM may be removed from the central macula region and a distal flap technique, such as superior wide-base ILM flap transposition (SWIFT), may be used.
Other techniques include single-layer inverted flap (as opposed to multilayer flaps), pedicle flaps, retracting door flap and tucking the ILM into the MH, among others.4,5,16 The latter may be associated with RPE trauma, interference with realignment of outer retina layers, intraretinal ILM remnants and suboptimal visual acuity.
SWIFT
In most refractory MHs, the ILM was removed in a previous surgery and rim-based ILM flaps aren’t usable. In these situations, a distal ILM flap may be obtained to cover the MH, but these flaps can be unstable and prone to displacement.
SWIFT is a distal-ILM flap technique in which a wide-base flap is harvested from the superior residual ILM and subsequently inverted to drape over the MH in a single layer (Figure 2, page 38).3 The wide base makes the flap stable, reducing the risk of tilting, rotation and displacement.
If there’s not sufficient residual ILM superiorly, the ILM flap may be harvested from the temporal residual ILM. In a series of MHs with high-risk characteristics, including refractory MHs with previously removed ILM, our group reported a 94 percent closure rate.3
Optimal visualization of the ILM during the surgery is required for flap techniques. Brilliant blue G or indocyanine green aid in visualizing the ILM during surgery. ICG also allows for postoperative visualization and evaluation of the flap status with fluorescence imaging.17 Manipulating the flap to maintain MH coverage may be challenging and typically involves a learning curve. Postoperative evaluation of the flap position helps surgeons refine their technique.
Other distal ILM flap techniques
 |
|
Figure 2. This patient with a full-thickness macular hole and distant history of traumatic maculopathy juxtafoveal subretinal fibrosis had pars plana vitrectomy, internal limiting membrane removal and superior wide-base ILM flap transposition (SWIFT) with gas tamponade. A) Baseline photograph shows full-thickness MH and adjacent subretinal fibrosis. B) Optical coherence tomography demonstrates the full-thickness MH with temporal and nasal subretinal fibrosis. C) and D) Postoperative OCT and photograph show the closed MH and adjacent subretinal fibrosis. E) Indocyanine green fluorescence imaging shows the ILM flap covering the MH. (Used with permission: Ophthalmol Retina. 2021;5:317-323) |
Other distal flap techniques include the free ILM flap, ILM pedicle flap and autologous lens capsule flap.4-6
• Free-ILM flap technique. This approach involves harvesting the flap from a distal site and placing it over the MH. The flap often moves with the intraocular fluid currents and may get caught in instruments. Tucking the ILM flap into the MH, while it may help to stabilize the flap, can cause RPE trauma and intraretinal or subretinal ILM entrapment once the MH closes.
• Inverted or noninverted pedicle ILM flaps. This technique has been used for the primary management of MHs. While some aren’t suitable for cases with previously removed ILM, others have been found useful for refractory MHs in which the ILM was removed from the central macula in a previous surgery. The technique involves peeling a narrow strip of distal ILM circumferentially and transposing it over the MH.5 The flap stays attached to the residual ILM through a narrow pedicle, reducing the risk of flap loss compared with the free-flap technique. However, distal pedicle flaps are prone to rotation and displacement.
• Autologous lens capsule flap technique. This technique involves obtaining a free flap from the posterior or anterior lens capsule in a pseudophakic eye or during
concomitant cataract surgery. Lens capsule flap techniques have similar challenges as free ILM flaps—mainly flap instability. A number of adjuvants may be used for intraoperative flap stabilization including viscoelastics, perfluorocarbon liquid and autologous blood or plasma with variable effectiveness.
Retina tissue manipulation
Retinal manipulation techniques aim to improve retinal tissue compliance around the MH. These techniques include:7, 8
- manually mobilizing the MH rim toward the center;
- gently massaging and stretching the MH rim and surrounding retina;
- relaxing microretinotomies; and
- inducing a localized retinal detachment through subretinal fluid infusion or MH hydrodissection.
Some of these techniques have become obsolete while others have gained popularity. They’re relatively easy to perform and can be used with other methods, including flap and patch techniques. They’re particularly useful when there’s no residual ILM available for a flap or when the visualization is inadequate for ILM peel and flap formation. Surgical trauma to the RPE and neurosensory retina is a potential risk.
Autologous retinal graft
|
|
Figure 3. A) Optical coherence tomography and fundus fluorescein angiogram one year after autologous retinal transplant in a patient with giant macular hole shows coverage of the MH by the retinal graft with integration of the graft tissue with the surrounding retina. B) Fluorescein angiogram demonstrates that the graft blood vessels are perfused. |
Dilraj Grewal, MD, and Tamir Mahmoud, MD, PhD, described harvesting an autologous retinal graft from the mid-periphery and transplanting it in an eye with a refractory myopic MH.10 Postoperative OCT showed MH coverage with structural integration into the surrounding retina. Other studies showed a high coverage rate and integration, vascularization and graft reperfusion, with variable vision outcomes.9,11,18
In autologous neurosensory retinal transplant (ART), the graft may be placed within the MH or under or over the MH rim (Figure 3). PFCL can stabilize the graft during surgery and afterward as a tamponade, with removal in two to three weeks. Other tamponade agents include gas and silicone oil.
ART is useful in myopic MH associated retinal detachment (mMH/RD) and in large refractory MHs with a potential for vision improvement. In the former, sealing the MH allows for retinal reattachment and significant visual improvement in many cases.14 Potential complications include graft displacement, retinal detachment and surgical trauma.
Human amniotic membrane graft
 |
To avoid harvesting retina tissue, Dr. Rizzo described human amniotic membrane (hAM) graft for refractory MHs.12 In a series that included eight eyes with refractory MH, the hAM plugged the MH in all eight eyes and VA improved.
The hAM graft patch is made 200 to 500 µm larger than the MH. Using a bimanual technique and PFCL for stabilization, the hAM is positioned over the MH with the chorion layer facing the RPE and the edges are tucked under the MH rim. Air, short- or long-acting gas or silicone oil have been used for postoperative tamponade. Refractory myopic MHs associated with retinal detachment and very large refractory MHs are suitable for hAM graft. Potential complications include graft displacement and surgical trauma to the RPE and retina. Choroidal neovascularization has been described following hAM graft.19
Observation
Although various technical modifications have resulted in improved anatomic success for refractory macular holes, visual improvement may not follow. Clinical indicators of a guarded visual prognosis include:
- RPE and chorioretinal atrophy affecting the central macular region;
- a thin flat rim to the MH; and
- loss of normal retinal architecture on optical coherence tomography.
When the potential benefits of surgery for refractory MHs don’t justify the risks or patient inconvenience, observation becomes an appropriate management option.
Bottom line
A number of factors determine the best surgical approach for managing a refractory MH, including the potential for visual improvement, ILM status, MH size and previous surgeries. Some of the techniques may be combined for optimal results. RS
REFERENCES
1. Michalewska Z, Michalewski J, Adelman RA, Nawrocki J. Inverted internal limiting membrane flap technique for large macular holes. Ophthalmology. 2010;117:2018-2025.
2. Michalewska Z, Michalewski J, Dulczewska-Cichecka K, Adelman RA, Nawrocki J. Temporal inverted internal limiting membrane flap technique versus classic inverted internal limiting membrane flap technique: A Comparative Study. Retina. 2015;35:1844-1850.
3. Tabandeh H, Morozov A, Rezaei KA, Boyer DS. Superior wide-baseinternal limiting membrane flaptransposition for macular holes: Flap status and outcomes. Ophthalmol Retina. 2021;5:317-323.
4. Morizane Y, Shiraga F, Kimura S, et al. Autologous transplantation of the internal limiting membrane for refractory macular holes. Am J Ophthalmol. 2014;157:861-869 e1.
5. Gekka T, Watanabe A, Ohkuma Y, et al. Pedicle internal limiting membrane transposition flap technique for refractory macular hole. Ophthalmic Surg Lasers Imaging Retina. 2015;46:1045-1046.
6. Chen SN, Yang CM. Lens capsular flap transplantation in the management of refractory macular hole from multiple etiologies. Retina. 2016;36:163-170.
7. Szigiato AA, Gilani F, Walsh MK, Mandelcorn ED, Muni RH. Induction of macular detachment for the treatment of persistent or recurrent idiopathic macular holes. Retina. 2016;36:1694-1698.
8. Felfeli T, Mandelcorn ED. Macular hole hydrodissection: Surgical technique for the treatment of persistent, chronic, and large macular holes. Retina. 2019;39:743-752.
9. Grewal DS, Charles S, Parolini B, Kadonosono K, Mahmoud TH. Autologous retinal transplant for refractory macular holes: Multicenter international collaborative study group. Ophthalmology. 2019;126:1399-1408.
10. Grewal DS, Mahmoud TH. Autologous neurosensory retinal free flap for closure of refractory myopic macular holes. JAMA Ophthalmol. 2016;134:229-230.
11. Moysidis SN, Koulisis N, Adrean SD, et al. Autologous retinal transplantation for primary and refractory macular holes and macular hole retinal detachments: The global consortium. Ophthalmology. 2021;128:672-685.
12. Rizzo S, Caporossi T, Tartaro R, et al. A human amniotic membrane plug to promote retinal breaks repair and recurrent macular hole closure. Retina. 2018;39:S95-S103.
13. Rahimy E, McCannel CA. Impact of internal limiting membrane peeling on macular hole reopening: A systematic review and meta-analysis. Retina. 2016;36:679-687.
14. Vaziri K, Schwartz SG, Kishor KS, et al. Rates of reoperation and retinal detachment after macular hole surgery. Ophthalmology. 2016;123:26-31.
15. Rizzo S, Tartaro R, Barca F, Caporossi T, Bacherini D, Giansanti F. Internal limiting membrane peeling versus inverted flap technique for treatment of full-thickness macular holes: A comparative study in a large series of patients. Retina. 2018;38 Suppl 1:S73-S78.
16. Finn AP, Mahmoud TH. Internal limiting membrane retracting door for myopic macular holes. Retina. 2019;39:S92-S94.
17. Tabandeh H. Fluorescence imaging of the ILM flap following macular hole surgery. Am J Ophthalmol Case Rep. 2021;24:101203.
18. Tabandeh H. Vascularization and reperfusion of autologous retinal transplant for giant macular holes. JAMA Ophthalmol. 2020;138:305-309.
19. Bamberger MD, Felfeli T, Politis M, et al. Human amniotic membrane plug for chronic or persistent macular holes. Ophthalmol Retina. 2022;6:431-433.



